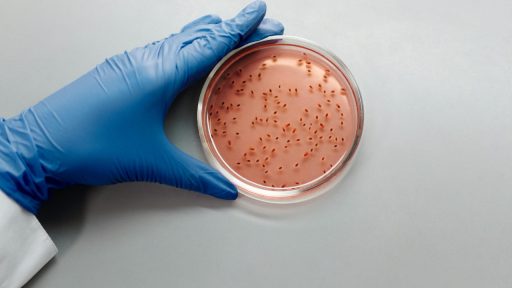
Bacterial MurJ Protein

Viruses that infect bacteria are exposing an unexpected vulnerability inside some of the toughest superbugs. By homing in on a tiny membrane protein called MurJ, these phages reveal a shared kill switch that shuts down the bacterial cell wall from within.
The finding is turning a basic question of microbiology into a concrete blueprint for new drugs. Rather than trying to outgun bacteria with ever broader antibiotics, researchers are learning from the precise protein weapons that phages already use to jam MurJ and collapse their hosts.
MurJ, the tiny transporter that keeps bacteria alive
MurJ sits buried in the bacterial inner membrane, yet it controls a life-or-death step for the cell. It flips a fatty molecule that carries peptidoglycan building blocks from the inside of the bacterium to the outside, where those bricks are woven into the rigid cell wall. Earlier work on Escherichia coli showed that this protein flips that lipid-linked cargo from one side of the membrane to the other, and that blocking this movement halts cell wall construction entirely, which makes MurJ an attractive target for new antibiotics that attack the wall assembly process from a different angle than older drugs.
In a detailed study of this pathway, researchers confirmed that MurJ is essential because it moves a specific peptidoglycan precursor and that cells die when this flipping step is disabled, which pointed directly to the idea that synthetic compounds could be designed to inhibit MurJ and thereby stop bacterial growth in strains that already evade existing therapies through resistance to other targets such as MraY or transpeptidases. Work from Bernhardt’s lab then developed a way to further test the effects of inhibiting MurJ using a toxin that some cells release, which strengthened the argument that MurJ is not just helpful but absolutely required for survival of E. coli and related pathogens and that any molecule capable of locking MurJ in place would have powerful antibacterial potential, as highlighted in a study of this.
Small phages and their single-gene lysis weapons
As chemists searched for molecules to hit MurJ, virologists were quietly discovering that some of the smallest phages had already solved that problem. The Clemons lab has turned some of its focus to single-stranded DNA and RNA phages, tiny phages with small genomes that require simple but potent strategies to burst their bacterial hosts. The weapons these small phages use to kill bacteria are protein antibiotics called single-gene lysis proteins, or Sgls (pronounced S-gels), and several of these Sgls converge on MurJ by binding to it and preventing it from making the structural changes needed to flip its cargo, effectively turning MurJ into a jammed switch.
Structural and biochemical work from the same group showed that when an Sgl binds MurJ, the transporter can no longer cycle between inward-facing and outward-facing states, which traps the peptidoglycan precursor on the inner side of the membrane and starves the cell wall of new material until the bacterium ruptures. Because these Sgls are encoded by single genes and act with high specificity, they function as protein antibiotics that nature has already optimized, and researchers are now mining phage genomes for more of these MurJ-targeting Sgls as a starting point for drug design, a strategy described in detail in the new insights into.
A shared kill switch revealed by LysM and other MurJ blockers
The idea of a shared kill switch inside MurJ has gained sharper definition as structural biology has caught up with phage genetics. One phage lysis protein, LysM, has been shown to act as a wedge that inserts into MurJ and restricts the flexibility of residue G239 in transmembrane helix 7, thereby limiting its bending and freezing the transporter in a nonfunctional conformation. In a detailed cryo-electron microscopy analysis, LysM functions as a conformational wedge in MurJ, which prevents the normal transport cycle and in turn prevents bacterial cell wall synthesis, a mechanism that explains how such a small protein can deliver a lethal blow to the cell.
This work revealed that MurJ must undergo specific bending and twisting motions to flip its lipid cargo and that different Sgls and lysis proteins exploit the same moving parts, which is why they cluster around similar helices and residues. A related preprint described the cryo-EM structure of the YES complex composed of Escherichia coli MraY, protein E, and additional components and noted that a major recent breakthrough revealed this complex as a second vulnerable point in the same cell wall pathway, but MurJ remains the transporter whose motion is directly hijacked by LysM and its relatives, as described in the YES complex analysis. Together, these findings support the idea that MurJ’s conformational cycle is a shared kill switch that different phage proteins have independently learned to jam.
From basic phage biology to next-generation antibiotics
What began as curiosity-driven work on obscure phages has quickly become part of the broader response to drug-resistant infections. Viruses may hold the blueprint for next-generation antibiotics, because their Sgls and lysis proteins already hit essential bacterial processes that current drugs barely touch, including MurJ and the early steps of peptidoglycan synthesis. In coverage of the growing threat of antibiotic resistance, researchers have emphasized that superbugs have a hidden weak spot in these underexplored transporters and that phage proteins provide ready-made templates for therapies that could bypass existing resistance mechanisms, a point highlighted in a report on the growing threat of.
Several teams are now exploring how to translate MurJ-targeting Sgls into practical treatments. One approach is to engineer phage therapy cocktails that combine traditional lytic phages with Sgl genes tuned to hit MurJ in specific pathogens, building on existing clinical efforts where phage therapy, using specific viruses to fight difficult bacterial infections, already shows promise for patients with multidrug-resistant Pseudomonas or Mycobacterium infections. Another strategy is to use the atomic details of Sgl binding sites on MurJ to guide small-molecule screening, so that chemists can design drugs that mimic the conformational wedge effect of LysM without needing to deliver a protein, a concept inspired by the detailed structural snapshots of MurJ and phage factors described in recent structural work.
Why MurJ’s vulnerability matters in the age of superbugs
The emergence of MurJ as a shared kill switch matters because it offers a way to outflank superbugs that have already accumulated resistance to multiple drug classes. Traditional antibiotics often target a handful of well-known enzymes, such as transpeptidases that cross-link peptidoglycan or ribosomes that drive protein synthesis, and bacteria have had decades to evolve defenses against those compounds. By contrast, MurJ and its associated transport complexes have been relatively untouched by clinical drugs, yet they are absolutely essential for cell wall construction, which means that even extensively resistant strains remain dependent on this vulnerable transporter, as highlighted in a discussion of hidden.
MurJ-focused research also illustrates how basic institutional infrastructure supports high-impact science. The work on single-gene lysis proteins and MurJ has been driven by groups that rely on specialized facilities, from cryo-EM suites to phage libraries, and institutions such as Caltech provide that environment through centers, shared resources, and programs that are accessible through platforms like Access Caltech and directories such as Directory Caltech, which connect researchers, trainees, and support staff. As these teams refine their understanding of how Sgls, LysM, and related proteins jam MurJ, they are effectively turning a viral survival trick into a roadmap for antibiotics that could one day reset the balance in hospitals where resistant infections currently outpace available drugs.